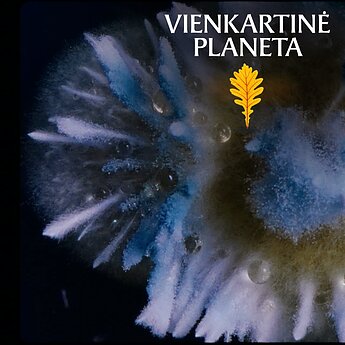
Kai filmo personažais tampa mikrogrybai

Naujienų srautas
Mokslas ir IT
Mokslas ir IT
2026.04.23 05:30
LRT pokalbis
Saulė išsipūs, išgarins jūras: Nobelio premijos laureatas – apie mūsų žvaigždės ateitį
„Turėtume daug labiau nerimauti dėl to, kad Saulės branduolinė energija senka, o per ateinančius kelis milijardus metų Saulė taps vis karštesnė ir išgarins mūsų vandenynus. Galiausiai baigsis Saulės energija, ji išsipūs ir sunaikins Žemę. Tikriausiai po 6 milijardų metų, plius minus milijardas“, – interviu LRT.lt sako 2011 metais Nobelio fizikos premija apdovanotas prof. Brianas Schmidtas. Astronomas kartu su kolegomis nustatė, kad mūsų Visata vis greičiau plečiasi. Tačiau įdomu, kad ta Visatos dalis, kurioje mes gyvename, yra tarsi sala arba kokonas, kuriame šis procesas nevyksta.
19
Skaitomiausi
Mokslas ir IT
2026.04.23 05:30
LRT pokalbis
Saulė išsipūs, išgarins jūras: Nobelio premijos laureatas – apie mūsų žvaigždės ateitį
19


Mokslas ir IT
2026.04.23 05:30
LRT pokalbis
Saulė išsipūs, išgarins jūras: Nobelio premijos laureatas – apie mūsų žvaigždės ateitį
19
Mokslas ir IT
2026.02.11 05:30
Išskirtinis interviu
Lietuviškų šaknų vokietė – apie pirmąjį pasaulyje vien tik moterų žiemojimą Antarktidoje
16
Mokslas ir IT
2026.01.30 05:30
Išskirtinis interviu
Europos astronautas – apie mėlynus žaibus kosmose, nesvarumą ir NASA planą pasiekti Marsą
10
Mokslas ir IT
2026.01.16 05:30
Tik LRT.LT
Senėjimas taps išgydomas? JK mokslininkai siekia patvirtinti pirmąjį pasaulyje vaistą
15